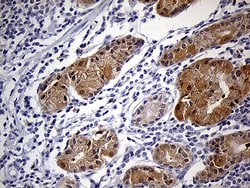
PRDX5 Monoclonal Antibody (OTI3B6), TrueMAB , OriGene 100 &mu;L; Unconjugated:Antibodies,

Learn More
PRDX5 Monoclonal Antibody (OTI3B6), TrueMAB™, OriGene
Mouse Monoclonal Antibody
Brand: Origene Technologies TA811474

Description
Peroxiredoxin (Prx) is a growing peroxidase family, whose mammalian members have been known to connect with cell proliferation, differentiation, and apoptosis. Many isoforms (about 50 proteins), collected in accordance to the amino acid sequence homology, containing active site cysteine residue, and the thiol-specific antioxidant activity, distribute throughout all the kingdoms. Among them, mammalian Prx consists of 6 different members grouped into typical 2-Cys, atypical 2-Cys Prx, and 1-Cys Prx. Except Prx VI belonging to 1-Cys Prx subgroup, the other five 2-Cys Prx isotypes have the thioredoxin-dependent peroxidase (TPx) activity utilizing thioredoxin, thioredoxin reductase, and NADPH as a reducing system. Mammalian Prxs are 20-30 kilodalton in molecular size and vary in subcellular localization: Prx I, II, and VI in cytosol, Prx III in mitochondria, Prx IV in ER and secretion, Prx V showing complicated distribution including peroxisome, mitochondria and cytosol.Specifications
| PRDX5 | |
| Monoclonal | |
| Unconjugated | |
| PRDX5 | |
| ACR1, AOEB166, B166, HEL-S-55, PLP, PMP20, PRDX6, PRXV, SBBI10, prx-V | |
| Mouse | |
| Affinity Chromatography | |
| RUO | |
| 25824 | |
| -20° C, Avoid Freeze/Thaw Cycles | |
| Liquid |
| Immunohistochemistry (Paraffin), Western Blot | |
| OTI3B6 | |
| PBS with 1% BSA, 50% glycerol and 0.02% sodium azide | |
| P30044 | |
| PRDX5 | |
| Full length human recombit protein of human PRDX5 produced in HEK293T cell. | |
| 100 μL | |
| Primary | |
| Human | |
| Antibody | |
| IgG2b |
The Fisher Scientific Encompass Program offers items which are not part of our distribution portfolio. These products typically do not have pictures or detailed descriptions. However, we are committed to improving your shopping experience. Please use the form below to provide feedback related to the content on this product.